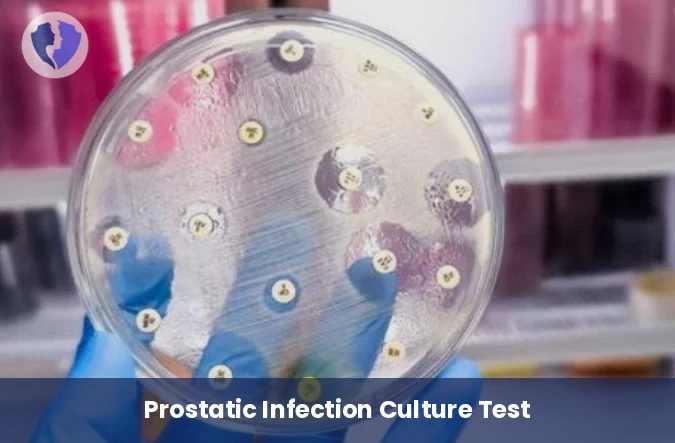
Prostatic Secretion Culture

Service Details
Prostatic Secretion Culture
A specialized diagnostic package for prostate infections (bacterial prostatitis). This includes quantitative culture of a urine sample after prostate massage (compared to other urine samples), or of a sample of prostatic secretion itself, on nutrient media. It also includes antibiotic susceptibility testing of the isolated bacteria to determine the most appropriate antibiotic for treatment, which must have good penetration of prostate tissue.